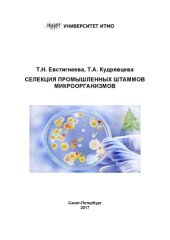
book Селекция промышленных штаммов микроорганизмов: Учебно-методическое пособие

- Author: Аверьянов Л.В. Кудрявцева Е.П.
- Language: Русский
- Year: 1987

- Author: Орехова Л.Ю. Улитовский С.Б. Кудрявцева Т.В.
- Language: Русский
- Year: 2005

- Author: Кудрявцева З. А. Ермолаева Е. В.
- Language: Русский

- Author: Кудрявцева Т. Ю.
- Language: Русский

- Author: Сальникова Е.В. Кудрявцева Е.А. Лебедев С.В. Скальная М.Г.
- Language: Русский